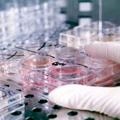

OECD Sağlık Verileri: Türkiye’deki hemşirelerin %76’sı yurt dışında çalışmak istiyor
Ekonomik Kalkınma ve İşbirliği Örgütü (OECD) Sağlık Verileri 2022’ye göre, Türkiye 100 bin nüfusa düşen toplam hemşire sayısında 43 ülke...
DevamıDr. House ![]() Tıbbi Mizah grubunda bir güncelleme yayınladı 13 yıl önce
Tıbbi Mizah grubunda bir güncelleme yayınladı 13 yıl önce
Dr. Enes Başak wrote a new post, Perinatal enfeksiyonlar tanı ve tedavisi 13 yıl 2 ay önce
Perinatal enfeksiyonlar tanı ve tedavisiPerinatal Enfeksiyonlar: Perinatal mortalite; IUGR, preterm doğum, kongenital anomaliler % 2-4. TORCH grubu; toxoplazma, rubella, cytomegalovirus, herpes. Patofizyoloji: İlk trimestir; embriyo kaybı, spontan abort, teratojenik malformasyon. İkinci, üçüncü trimestir; preterm eylem, arachidonic asit (PGE2 ye metabolize olur), IL1 artar > PGE2 artar, TNF artar. Fetus gebelik boyunca antijenik uyarıdan korunur.
Perinatal enfeksiyonlar tanı ve tedavisiPerinatal Enfeksiyonlar: Perinatal mortalite; IUGR, preterm doğum, kongenital anomaliler % 2-4. TORCH grubu; toxoplazma, rubella, cytomegalovirus, herpes. Patofizyoloji: İlk trimestir; embriyo kaybı, spontan abort, teratojenik malformasyon. İkinci, üçüncü trimestir; preterm eylem, arachidonic asit (PGE2 ye metabolize olur), IL1 artar > PGE2 artar, TNF artar. Fetus gebelik boyunca antijenik uyarıdan korunur.